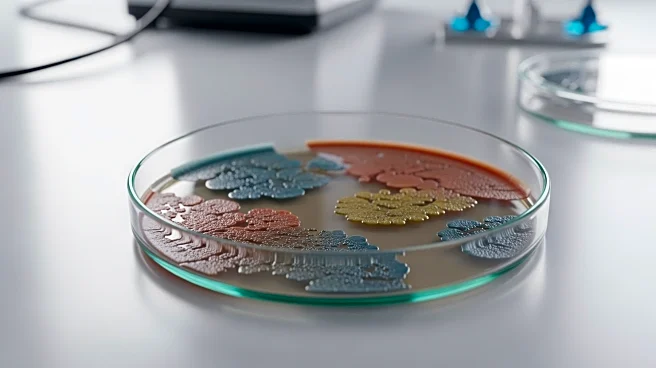
News banner

Rapid Read • 7 min read
Air Canada faced a significant disruption as 10,000 flight attendants initiated a strike demanding better wages. The strike led to the cancellation of 700 flights, affecting approximately 130,000 passengers daily. The Canadian government, recognizing the potential for widespread travel chaos, intervened by imposing binding arbitration to halt the strike. Labor Minister Patty Hajdu announced that an independent industrial labor relations board would review the situation within 24 to 48 hours before issuing a back-to-work order. Air Canada, which had locked out the striking workers, indicated that it would take an additional five to ten days to restore full service.
AD
The strike at Air Canada highlights the ongoing labor disputes within the airline industry, which can have significant repercussions on travel and the economy. The disruption affects not only Canadian travelers but also international passengers, given Air Canada's role as a major airline. The government's intervention underscores the critical nature of maintaining operational stability in the airline sector, which is vital for economic activity and connectivity. The resolution of this dispute could set a precedent for future labor negotiations in the industry, impacting wage standards and working conditions for airline employees.
The immediate next step involves the independent labor board's review and the issuance of a back-to-work order. Air Canada will need to coordinate efforts to resume operations, which could take up to ten days. The outcome of the arbitration process will be closely watched by other airlines and labor unions, as it may influence future negotiations. Passengers affected by the cancellations will be seeking alternative travel arrangements, and the airline will need to manage customer relations carefully to mitigate dissatisfaction.
AD
More Stories You Might Enjoy